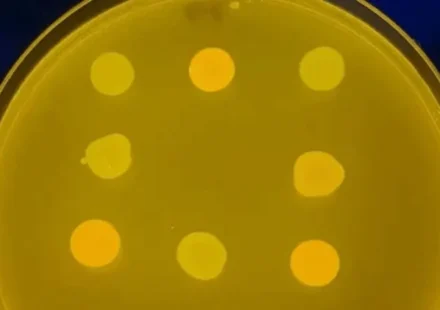

Загадочный радиокруг поставил новый рекорд и озадачил ученых
Космическая тайна становится все глубже: астрономы обнаружили самый далекий и мощный «странный радиокруг» из когда-либо зарегистрированных. Гигантская космическая загадка становится все масштабнее. Эти редкие небесные кольца, представляющие собой…
Читать далееВиды ракет: 7 типов по двигателям и назначению
Ракетная двигательная установка — это увлекательная технология. Технология, которая генерирует достаточную тягу для перемещения летательных аппаратов по воздуху. Но знаете ли вы, что ракетная технология была изобретена китайцами в 13 веке? Конечно,…
Читать далееМарсианский зонд ОАЭ «Надежда» вышел на цель
Из трех новых марсианских миссий, запланированных на этот год, зонд Hope из Объединенных Арабских Эмиратов (ОАЭ) первым достигнет Красной планеты. Размещенный на высокой эллиптической орбите, зонд будет нацелен на изучение своей атмосферы. Скорое…
Читать далееJAXA испытает надувные щиты для посадки марсоходов на Марс
Институт космических и астронавтических наук (ISAS) Японского космического агентства (JAXA) разрабатывает новую концепцию миссии по отправке небольших марсоходов на поверхность Марса. Этот проект предполагает использование надувных аэрооболочек (тепловых…
Читать далееFalcon Heavy успешно посадил все три ускорителя после старта
По сообщению Associated Press, все три ракетных ускорителя Falcon Heavy, запущенные SpaceX в четверг вечером на мысе Канаверал во Флориде, успешно приземлились. Через восемь минут после запуска два из бумеров приземлились на мысе Канаверал, как и в…
Читать далееФотонные двигатели: реальный шанс долететь до других звезд
Как использовать свет, чтобы создать двигатель, способный доставить нас к другим звездам? Почему этот способ считают одним из наиболее перспективных? В этом выпуске поговорим о различных типах световых…
Читать далееПищевые жиры, попадающие в мозг, могут объяснить связь между ожирением и депрессией.
Ожирение и депрессия уже давно связаны с предыдущими клиническими исследованиями, которые обнаружили связь между этими двумя состояниями. Однако до настоящего времени механизмы влияния ожирения на депрессию и наоборот не были полностью поняты. Теперь, в…
Читать далееАстрономы пересмотрели размеры Млечного Пути в большую сторону
Новое компьютерное моделирование предполагает, что Млечный Путь на самом деле в семь раз шире, чем предыдущие оценки. Мы склонны устанавливать границы, основываясь на том, что мы видим на самом деле. Но иногда невидимое также может оказывать влияние.…
Читать далееПо данным ВОЗ, случаи повторного заражения Covid-19 были ложноположительными
Пациенты, которые, как сообщается, излечились от Covid-19 и снова испытывали положительный результат на болезнь, фактически вытесняют мертвые клетки легких, сообщает Всемирная организация здравоохранения (ВОЗ) в среду. Таким образом, предположение о…
Читать далееМарсоход NASA подтвердил: кратер Езеро был озером на древнем Марсе
Несколько лет назад НАСА выбрало кратер Езеро в качестве площадки для своего марсохода Персеверанс, целью которого является поиск прошлой жизни на Марсе. Место было выбрано на основании спутниковых снимков, свидетельствующих о том, что в этом районе…
Читать далееВ США впервые провели двойную трансплантацию легких с использованием робота
Врачи медицинского центра NYU Langone Health в Нью-Йорке впервые в мире успешно провели полную двойную трансплантацию легких с использованием роботизированной системы. Операция была выполнена 22 октября 2024 года на 57-летней пациентке Шерил Меркар,…
Читать далееГенетически модифицированные бактерии обыграли ученых в крестики-нолики
html Копировать Скачать Запустить Представьте себе бактерию, которая пытается обыграть вас в крестики-нолики. Звучит как сюжет для научно-фантастического рассказа, не так ли? И тем не менее, ученые умудрились превратить обычную кишечную палочку…
Читать далееУченые доказали передачу мутаций ДНК от ликвидаторов Чернобыльской аварии их детям
Ученые впервые обнаружили, что мутации ДНК, вызванные ионизирующим излучением в результате аварии на Чернобыльской АЭС 1986 года, передаются следующему поколению — детям тех, кто подвергся облучению. Хотя предыдущие исследования не могли однозначно…
Читать далееЧерная дыра-беглец и планета в недрах Земли: главные новости космоса
Внутри Земли сохранилась значительная часть планеты Тейя? Сверхмассивная черная дыра несётся по вселенной! Что происходит с ближайшим к Земле звездным скоплением? Это и многое другое в новом выпуске…
Читать далее